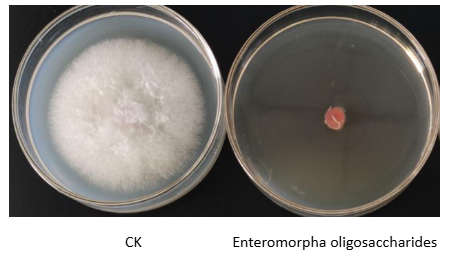
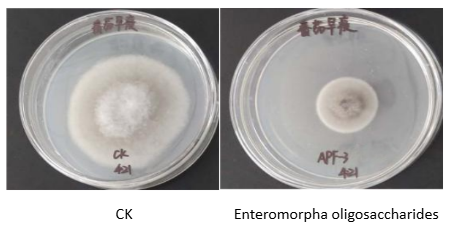

Annual global crop losses caused by diseases reach 20%–40%. Excessive reliance on chemical pesticides not only accelerates pathogen resistance, but also leads to environmental pollution and food safety risks. The development of green, efficient plant immunity inducers and bio-based fungicides has therefore become an urgent requirement for sustainable agriculture.
As a leading enterprise in the development of marine bioactive substances, Seawin Biotech Group leverages its independently controlled green algae germplasm resource bank to break through the homogenized competition that has long constrained conventional oligosaccharide products. Through its self-developed targeted enzymatic hydrolysis patented technologies, the company has taken the lead in achieving large-scale, precision production of green algae oligosaccharides ---- compared with commonly available oligosaccharides on the market, green algae oligosaccharides exhibit distinctive biological activity in plant immune activation and coordinated pathogen suppression, owing to their unique and diverse backbone structures and natural sulfation modifications.
This series of articles will systematically analyze the natural disease resistance mechanism of green algae oligosaccharides and explore the key in its transition from the laboratory to the field.
Structural Features of Green Algae Oligosaccharides
Green algae oligosaccharides are molecular fragments with a degree of polymerization (DP) of 2–20, obtained through enzymatic hydrolysis or chemical degradation of polysaccharides derived from green algae (such as Ulva, Enteromorpha, and Chaetomorpha)
Their core structural characteristics include:
Backbone diversity: Depending on their biological origin, green algae oligosaccharides mainly include α-1,3-rhamno-oligosaccharides (degradation products of intercellular matrix polysaccharides from Enteromorpha), β-1,4-manno-oligosaccharides (derived from cell wall polysaccharides of Chaetomorpha), as well as mixed-linkage oligosaccharides composed of glucuronic acid–xylose–rhamnose and xylose–galactose–arabinose units.
Rich functional groups: Green algae oligosaccharides naturally carry abundant hydroxyl groups, carboxyl groups (from uronic acid units), and sulfate ester groups (such as rhamno-oligosaccharide sulfates), endowing them with strong hydrophilicity and high chemical reactivity.
Precisely controlled molecular weight: Through the use of specific glycosidic bond–cleaving enzymes and other targeted enzymatic hydrolysis technologies, green algae polysaccharides can be directionally converted into bioactive oligosaccharide fractions with defined degrees of polymerization.
Green algae oligosaccharides exhibit dual disease-resistance activity: the synergistic combination of immune activation and targeted antimicrobial action.
1. Plant Immunity–Inducing Activity
Green algae oligosaccharides act as pathogen-associated molecular patterns (PAMPs). They are specifically recognized by pattern recognition receptors (PRRs) on the plant cell membrane, thereby triggering a cascade of immune responses:
(1) Early signaling events
①Calcium ion (Ca²⁺) signaling burst
②Reactive oxygen species (ROS) burst
③Mitogen-activated protein kinase (MAPK) phosphorylation cascades (such as MPK3/MPK6)
(2) Regulation of Defense Gene Expression
①Salicylic acid (SA) pathway: Upregulates the expression of pathogenesis-related proteins PR1 and PR2 (β-1,3-glucanase), thereby inducing systemic acquired resistance (SAR).
②Jasmonic acid (JA) / Ethylene (ET) pathway: Enhances the expression of genes such as protease inhibitors (PI-II), strengthening resistance against chewing insects and necrotrophic pathogens.
③Phenylpropanoid metabolic pathway: Promotes the activity of lignin biosynthesis–related enzymes (such as PAL and 4CL), leading to cell wall thickening.
2. Antimicrobial Activity
Green algae oligosaccharides exhibit direct inhibitory effects against a broad range of plant pathogens, with their antimicrobial efficacy arising from multiple complementary mechanisms:
(1) Physical disruption: Negatively charged carboxylated oligosaccharides adsorb onto microbial cell surfaces via electrostatic interactions, thereby altering membrane permeability.
(2) Metabolic interference: Sulfated oligosaccharides competitively inhibit fungal chitin synthase activity.
(3) Quorum sensing inhibition: Green algae oligosaccharides with specific degrees of polymerization and structural features can interfere with pathogen signaling molecule transmission, leading to a significant downregulation of virulence factor expression.
Case study: Plate confrontation assays showed that Enteromorpha-derived oligosaccharides at a concentration of 10 mg/mL achieved an inhibition rate of up to 95.7% against wheat Fusarium head blight and up to 70.5% inhibition against tomato early blight.
Figure 1 Inhibit Wheat Fusarium Head Blight
Figure 2 Inhibit Tomato Early Blight
Green algae oligosaccharides, with their unique dual disease-resistance mechanisms, provide a new strategy for green crop protection. However, unmodified green algae oligosaccharides inherently suffer from certain limitations, including insufficient stability, high activity thresholds, and limited targeting capability. These challenges make structural optimization through molecular engineering essential—an approach that will be explored in the next article, “Structural Modification and Activity Enhancement.”
By precisely modifying active sites such as hydroxyl and carboxyl groups, Seawin Biotech is endowing these marine-derived molecules with improved stability, enhanced targeting, and superior cost efficiency, accelerating their transition from the laboratory to field applications.
Supplementary background
Enteromorpha is a green macroalga belonging to the Ulvaceae family. It is rich in nutrients beneficial to human health and has long been used as an edible seaweed resource in East Asia. Enteromorpha is characterized by high protein content and is abundant in dietary fiber, vitamins, and minerals. More importantly, it contains a range of bioactive compounds, including polysaccharides and polyphenols, which are associated with potential health benefits such as antioxidant activity and immune modulation.
Since the summer of 2008, large-scale blooms of Enteromorpha have occurred repeatedly in the Yellow Sea and Bohai Sea of China, forming massive “green tides” that pose significant challenges to coastal ecosystems and landscapes. Against this backdrop, Seawin Biotech, leveraging the scientific strengths of Ocean University of China, took the lead in establishing a full industrial chain covering professional offshore harvesting, efficient onshore processing, and high-value utilization.
Through proprietary technologies, the company converts bloom-season Enteromorpha into stable, high-quality raw materials, further developing them into feeding additive, food ingredients, agricultural inputs, and biological products. This approach has enabled the large-scale, resource-based utilization of Enteromorpha, effectively turning an environmental challenge into economic and ecological value—truly realizing Green and Sustainable Development.
Booth No. 22H18 – See you at CAC 2026!
Contact:eileen.wang@coub.cn
Tel: 86-532-85901608
Website: www.seawin-bio.com
Linkedin: https://www.linkedin.com/company/qingdao-seawin-biotech-group
FaceBook: https://www.facebook.com/profile.php?id=100064125487612




